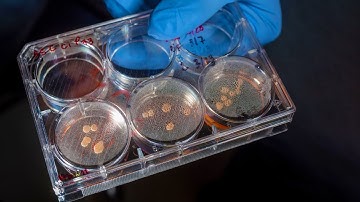
Scientists grow mini brains with eyes in lab || mini brain with eyes

⬇ DOWNLOAD NOW
Kalau muncul iklan pop-up, tutup lalu klik tombol kembali
Download lagu Growing "Mini-Brains" in a Lab: Human Brain Organoids secara gratis hanya untuk keperluan promosi. Dukung artis favorit kamu dengan membeli musik original di iTunes atau platform resmi lainnya.
 Scientists Grow Mini Brains in the Laboratory! | Brain organoids
Scientists Grow Mini Brains in the Laboratory! | Brain organoids
Scientists grow mini brains with eyes in lab || mini brain with eyes
Scientists grow mini brains with eyes in lab || mini brain with eyes
 How lab-grown 'mini-brains' can help prevent motor neurone disease
How lab-grown 'mini-brains' can help prevent motor neurone disease
 Growing mini-brains in the lab?? The science of cerebral organoids!
Growing mini-brains in the lab?? The science of cerebral organoids!
 What are mini brains? - Madeline Lancaster
What are mini brains? - Madeline Lancaster
 How to Grow Cerebral Organoids from Human Pluripotent Stem Cells
How to Grow Cerebral Organoids from Human Pluripotent Stem Cells
 Lab-grown brain cells play Pong video game after learning with real-time performance feedback
Lab-grown brain cells play Pong video game after learning with real-time performance feedback
 Making Brain Organoids: A Primer
Making Brain Organoids: A Primer